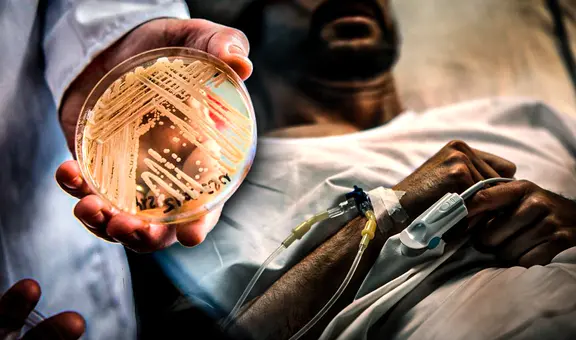
Candida auris: ¿por qué es considerado como "amenaza urgente" en Estados Unidos?

¿Cómo es la 'segunda varicela', que aparece en 1 de cada 3 adultos?
Años después de haber contraído varicela, el virus puede reactivarse y causar una infección similar llamada herpes zóster. ¿En qué casos ocurre y cómo podemos prevenirla?
- Científicos suizos podrían cambiar el futuro de la electrónica cuántica con circuitos controlados por luz
- Científicos descubren una nueva especie de pulpo en las aguas del Pacífico y sería exclusiva en un país de América Latina

Cuando contraes varicela por primera vez, el virus de la varicela-zóster (VVZ) —patógeno que provoca dicha infección— logra esconderse dentro de tu organismo y permanece allí el resto de tu vida. Si bien casi siempre está inactivo, puede reactivarse cuando las defensas del huésped disminuyen, una situación que generalmente suele suceder en la adultez.
Pero su contraataque ya no causa varicela, sino herpes zóster, una enfermedad infecciosa que, aunque provoca unas heridas similares a las de la varicela, es un tanto diferente a ella. Según un estudio de 2021, uno de cada tres adultos la padecerán en el transcurso de su vida.
¿Qué es el herpes zóster?
El herpes zóster —también llamado culebrilla o 'segunda varicela'— se caracteriza por la aparición de erupciones cutáneas que evolucionan en ampollas llenas de agua y, en la última etapa, en costras. Durante la infección, estas heridas pican, arden y hasta pueden causar un dolor insoportable.

El herpes zóster o culebrilla es causado por el mismo virus que causa la varicela. Foto: Dermatology Online Journal
La culebrilla también suele ser acompañada por síntomas como fiebre, dolor de cabeza y fatiga.
Si bien el herpes zóster ocurre con mayor frecuencia en personas mayores de 50 años, también puede darse en adultos jóvenes que enfrentan situaciones muy estresantes o toman medicamentos inmunosupresores o en niños con enfermedades que debilitan su sistema inmune.
¿En qué se diferencia de la varicela?
La diferencia entre el herpes zóster y la varicela es que los sarpullidos no se manifiestan en todo el cuerpo, sino de manera local, principalmente, en una o más franjas del cuerpo inervadas por una raíz dorsal del nervio espinal.

Las heridas del herpes zóster suelen aparecer en una o más franjas del cuerpo que son inervadas por el nervio espinal. Foto: Medspine
Por lo general, las ampollas aparecen formando una especie de cinturón en el lado derecho o izquierdo del torso —de allí el nombre de culebrilla—, aunque, en un número menor de casos, también se puede manifestar en el cuello, la cara o cerca a los ojos.
Otra diferencia entre ambas infecciones es que, mientras la varicela puede ser mortal —principalmente cuando ocurre en adultos—, el herpes zóster no es tan agresivo y sus síntomas suelen desaparecer entre dos y seis semanas, indica Mayo Clinic, una prestigiosa institución médica de los Estados unidos.
¿La culebrilla es contagiosa?
Los pacientes con herpes zóster pueden transmitir el virus VVZ a cualquier persona que no sea inmune a la varicela, por ejemplo, un recién nacido. No obstante, cabe destacar que el contagio, por lo general, sucede a través del contacto directo con las llagas abiertas del sarpullido.
¿Cómo prevenir el herpes zóster?
La mejor forma de prevenir la 'segunda varicela' es con una vacuna. El inmunizante desarrollado recientemente se llama Shingrix. Esta usa un virus inactivado para potenciar y extender la respuesta inmunitaria contra el virus VVZ.
En ensayos realizados en España, se ha demostrado que la vacuna Shingrix previene nueve de cada 10 casos de herpes zóster en mayores de 50 años, indica un artículo de The Conversation.
Otra vacuna alternativa es Zostavax, la cual se encuentra disponible en Perú. No obstante, esta no es tan efectiva como Shingrix.